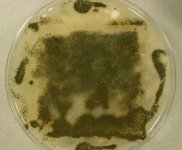

Search Details
| UAMH Number: | 7142 |
|---|---|
| Species Name: | Chaetomium globosum |
| Type: | |
| Synonyms: | Chaetomidium barbatum / Chaetomium affine / Chaetomium fibripilium / Chaetomium globosum var. affine / Chaetomium kunzeanum / Chaetomium kunzeanum var. chlorina / Chaetomium lusitanicum / Chaetomium mollipilium / Chaetomium ochraceum / Chaetomium olivaceum / Chaetomium rectum / Chaetomium spiculipilium / Chaetomium spirale / Chaetomium subglobosum / Chaetomium subterraneum |
| Taxonomy: | FUNGI Ascomycota, Sordariomycetes, Sordariales, Chaetomiaceae |
| Strain History: | Poznanski, S. (18) -> UAMH |
| Substrate: | indoor air, RCS strip | Location: | CANADA Alberta, Edmonton (GEO: 53.544,-113.491) |
| Isolator: | L. Sigler (18b) |
| Isolation Date: | 1989-10-16 |
| Date Received: | 1992-06-01 |
| Characters: | APPLICATION antigenic chitosanases having potential as biomarkers for detecting C. globsum in indoor environment - Provost NB, Shi C, She Y-M, Cyr TD, Miller JD, Med Mycol 2012 DOI:10.3109/13693786.2012.715246 // APPLICATION highest immunoblot response among human polyclonal antibodies tested - Provost et al 2012 // APPLICATION metabolites chaetoglobosins and azaphilones produced by strains from the indoor environment - McMullin DR, Sumarah MW, Miller JD, Mycotoxin Res 2012 DOI 10.1007/s12550-012-0144-9 // SYSTEMATICS/ TAXONOMY comparison with C. strumarium - Abbott, Sigler, McAleer, et al, J. Clin. Microbiol. 33: 2692-2698, 1995 (Click for publications citing UAMH 7142) |
| Compounds: | CHAETOGLOBOSIN A, F, C, CHAETOMUGILIN D, CHAETOVIRIDIN A McMullin DR, Sumarah MW, Miller JD, Mycotoxin Res 2012 DOI 10.1007/s12550-012-0144-9 |
| Cross Reference: | |
| Collections: | Living Strains; Dried Herbarium Material |
| Pathogenic Potential: | Human: no | Animal: no | Plant: no |
| Biosafety Risk Group: | RG1 (check the PHAC ePATHogen Risk Group Database for updates) |
| Regulatory Requirements: | Canadian requesters must provide PHAC Pathogen and Toxin License Number (see: https://www.canada.ca/en/public-health/services/laboratory-biosafety-biosecurity/licensing-program.html) prior to shipment. International requesters must provide all legally required importation documentation prior to shipment. Plant pathogenicity status may be verified by using the USDA Agricultural Research Service (ARS) Fungal Database |
| MycoBank ID: | 172545 |
| Sequences: | >UAMH07142_JX130366_ITS ATTACAGAGTTGCAAAACTCCCTAAACCATTGTGAACGTTACCTATACCGTTGCTTCGGCGGGCGGCCCCGGGGTTTACCCCCCGGGCGCCCCTGGGCCCCACCGCGGGCGCCCGCCGGAGGTCACCAAACTCTTGATAATTTATGGCCTCTCTGAGTCTTCTGTACTGAATAAGTCAAAACTTTCAACAACGGATCTCTTGGTTCTGGCATCGATGAAGAACGCAGCGAAATGCGATAAGTAATGTGAATTGCAGAATTCAGTGAATCATCGAATCTTTGAACGCACATTGCGCCCGCCAGCATTCTGGCGGGCATGCCTGTTCGAGCGTCATTTCAACCATCAAGCCCCCGGGCTTGTGTTGGGGACCTGCGGCTGCCGCAGGCCCTGAAAAGCAGTGGCGGGCTCGCTGTCGCACCGAGCGTAGTAGCATACATCTCGCTCTGGAGGGGCCGCGGGTTCCGGCCGTTAAACCACC >UAMH07142_AY625061_SSU-LSU TCCGTTGGTGAACCAGCGGAGGGATCATTACAGAGTTGCAAAACTCCCTAAACCATTGTGAACGTTACCTATACCGTTGCTTCGGCGGGCGGCCCCGGGGTTTACCCCCCGGGCGCCCCTGGGCCCCACCGCGGGCGCCCGCCGGAGGTCACCAAACTCTTGATAATTTATGGCCTCTCTGAGTCTTCTGTACTGAATAAGTCAAAACTTTCAACAACGGATCTCTTGGTTCTGGCATCGATGAAGAACGCAGCGAAATGCGATAAGTAATGTGAATTGCAGAATTCAGTGAATCATCGAATCTTTGAACGCACATTGCGCCCGCCAGCATTCTGGCGGGCATGCCTGTTCGAGCGTCATTTCAACCATCAAGCCCCCGGGCTTGTGTTGGGGACCTGCGGCTGCCGCAGGCCCTGAAAAGCAGTGGCGGGCTCGCTGTCGCACCGAGCGTAGTAGCATACATCTCGCTCTGGTCGCGCCGCGGGTTCCGGCCGTTAAACCACCTTTTAACCCAAGGTTGACCTCGGATCAGGTAGGAAGACCCGCTGAACTTAA |
IMAGES: